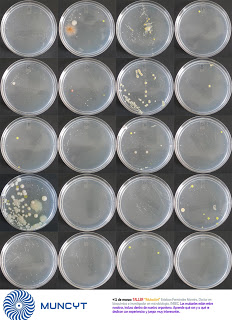

En 2010 realizamos talleres de teatro científico para los alumnos de la "Escola Superior de Arte Dramático de Galicia" en Vigo. Durante estos talleres se dieron nociones de mutación, transmisión horizontal y sobre qué es una bacteria, al mismo tiempo que se les instruyó para representar la obra "Comando Antibiótico" que pudieron representar cada uno 5 veces de manera remunerada.
---------------------------------------------------------------------------------------------------------------En Marzo de 2011 celebré dos talleres sobre mutación en el Museo Nacional de Ciencia y Tecnología en Madrid
En mayo 2017 se realizó un taller de divulgación científica en el marco del Primer Congreso de Salud Centrada en la Comunidad
--------------------------------------------------------------------------------------------------------------------
Pecha Kucha en el café de Macondo, 13 de Junio 2014 A Coruña: Filtros de agua artesanos: tecnología neolítica para un problema del SXXI from Esteban Fernández Moreira
--------------------------------------------------------------------------------------------------------------------Los puntos científicos son actividades de ciencia en la calle de dos horas de duración en donde científicos pertenecientes a la AGC CCT realizan actuaciones de 10 minutos. La primera que realizamos la hicimos en Ourense en el 2011 durante los carnavales, de ahí que muchos de nosotros fuésemos disfrazados.
------------------------------------------------------------------------------------------------------------------------
Charla en el CEIP Zalaeta, 19/5/2010. Nando Lestón y Esteban Fernández representan el cuento "Las semillas mágicas". Los niños participaron y parecía que se lo pasaron bien. De doce chavales a los que les pregunté si les había gustado, doce me dijeron que no. Lo que se dice una "learning experience" para mi, Nando se lo pasó igualmente bien, pero es que Nando es de Carnota y viene con la autoestima alta de serie.
Charla en el CEIP Zalaeta, 19/5/2010. Nando Lestón y Esteban Fernández representan el cuento "Las semillas mágicas". Los niños participaron y parecía que se lo pasaron bien. De doce chavales a los que les pregunté si les había gustado, doce me dijeron que no. Lo que se dice una "learning experience" para mi, Nando se lo pasó igualmente bien, pero es que Nando es de Carnota y viene con la autoestima alta de serie.
-----------------------------------------------------------------------------------------------------------------------------
Mesa redonda celebrada en la Escuela Superior de Arte Dramático de Galicia. Asistentes Arantxa Villar; Pío González; Vicente de Souza; Xurxo Mariño y Manuel Vicente entre otros-----------------------------------------------------------------------------------------------------------------------------
-------------------------------------------------------------------------------------------------------------------------------------
Esteban disfrazado de bacteria en el Punto Científico de Lira (Carnota) febrero 2013------------------------------------------------------------------------------------------------------------------------------------
Teatro, música, vídeos... e moita, moita divulgación científica
A Coruña, 15 de febreiro de 2013.- No marco do festival de curtametraxes “Por amor á arte”, a Asociación Galega de Comunicación de Cultura Científica e Tecnolóxica (AGCCCT) –agrupación sen ánimo de lucro constituída en abril de 2011- organiza un Punto Científico, un novo formato de divulgación científica que combina mini-charlas e obradoiros con outros formatos como o teatro, a música e o audiovisual.
Despois do éxito de anteriores edicións do Punto científico en Ourense e Carnota, nesta ocasión o espazo escollido para albergar o evento é a Domus (Ángel Rebollo, 91, A Coruña), onde familias e público xeral poderán gozar dun espectáculo singular.
O programa, no que participan fundamentalmente socios da asociación, incluirá teatro científico, música en directo, proxección de vídeos de animación 3D e mini-pílulas divulgativas, co obxectivo de achegar o coñecemento científico e tecnolóxico á poboación en xeral dun xeito lúdico. A entrada é de balde ata completar aforo. A duración do evento é de aproximadamente dúas horas, non entanto, o público poderá entrar e saír libremente en función dos seus intereses.
Unha opción entretida e educativa para pasar a tarde do venres
Que mellor opción para pasar a tarde do venres que disfrutando dun espectáculo de teatro, música, audiovisual e todo iso aderezado por unha alta dose de divulgación científica? Pois o programa deste Punto Científico inclúe todo iso. Luisa Martínez, científica mariña e responsable da Unidade de Cultura Científica do CSIC en Galicia, interpretará a peza de teatro científico “Que traballo tan curioso?” e Esteban Fernández, microbiólogo e promotor do proxecto Actuaciencia (teatro, radio, blog, etc.), a obra “Todo por unha eñe”.

b
ResponderEliminar